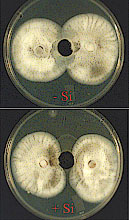

|
|

Introduction
Silicon (Si) is the second most abundant mineral element in soil comprising approximately 28% of the earth's crust (11,12,63). In warm sub-humid and humid tropical ecoregions (24), a high degree of weathering, mainly as desilication, has resulted in the development of soil orders rich in iron and aluminum oxides and low in nutrient bases and Si (Fig. 1) (32).
| |

Fig. 1. A simplified acid weathering sequence in soils. Source: Friesen et al. (17). Reprinted from Advances in Agronomy, Vol. 58, Savant, N. K., Snyder, G. H., and Datnoff, L. E., Silicon management and sustainable rice production, p. 157, 1997, with permission from Elsevier. |
|
Some of these soil orders such as Ultisols and Oxisol account for 34% of the area of major soil orders in the tropics. These orders occupy great amounts of land (approximately 1,666 million hectares) in Africa and South and Central America (Fig. 2). Histosols and sandy Entisols also contain low levels of Si (57). As a result of Si leaching, the soluble Si content of tropical soils, such as Ultisols and Oxisols, is generally less than in most temperate soils (16). This might be one of the unidentified causes of lower rice productivity of many tropical/subtropical soils compared to with that of temperate soils (56). Although most soils can contain considerable levels of Si, repeated cropping can reduce the levels of plant-available Si to the point that supplemental Si fertilization is required for maximum production.
| |

Fig. 2. Abundance of four soil orders in three important continents where rice is grown. Ultisols and Oxisols are characteristically low in plant available silicon. Adapted from Sanchez (54). |
|
Many plants are able to absorb Si. Depending upon the species, the content of Si accumulated in the biomass can range from 10 to greater than 100 g/kg (11,12). Plant species are considered Si accumulators when the concentration of Si (in dry weight basis) is greater than 1 g/kg (13). Relative to monocots, dicots such as tomato, cucumber, and soybean are considered to be poor accumulators of Si with values less that 1 g/kg in their biomass. Dryland grasses such as wheat, oat, rye, barley, sorghum, corn, and sugarcane contain about 10 g/kg in their biomass, while aquatic grasses have Si content up to 50 g/kg (12,13,31,52).
Silicon is accumulated at levels equal to or greater than essential nutrients in plant species belonging to the families Poaceae, Equisetaceae, and Cyperaceae (57). In rice, for example, Si accumulation is about 108% greater than that of nitrogen. It is estimated that a rice crop producing a total grain yield of 5000 kg/ha will remove Si at 230 to 470 kg/ha from the soil (57). Therefore, applications of calcium silicate at 5000 kg/ha (Si at 1000 kg/ha) appear to be sufficient for supplying enough Si to the plant so that the tissue content will be 3% or greater (64). Concentrations between 3 and 5% may be the minimum tissue levels needed for disease control (7).
Silicon is considered a plant nutrient "anomaly" because it is presumably not essential for plant growth and development (12). However, soluble Si has enhanced the growth, development and yield of several plant species including Equisetum, rice, sugarcane, wheat, and some dicotyledonous species (11,31,57). Plants absorb Si exclusively as monosilicic acid, also called orthosilicic acid (H2SiO4), by diffusion and also by the influence of transpiration-induced root absorption known as mass flow (11).
The content of Si in rice shoots cannot be accounted for only by diffusion and transpiration (11). The concentration of Si in the xylem of rice is usually many times higher than that of the soil solution; indicating that the uptake of Si might be metabolically driven (68). In rice, additive and non-additive genes seem to be involved in the mechanism of Si absorption (43). Silicon is deposited in the form of silica gel or biogenetic opal as amorphous SiO2·nH2O in cell walls and intercellular spaces of root and leaf cells as well as in bracts (38,75,76). Silicon also can be found in the form of monosilicic acid, colloidal silicic acid, or organosilicone compounds in plant tissues (23,76).

Fig. 3. Upland rice vigor and development in plots receiving application of calcium silicate (B) or not (A) in Colombia. |
|
The beneficial effects of Si to plants under biotic and/or abiotic stresses have been reported to occur in a wide variety of crops such as rice, oat, barley, wheat, cucumber, and sugarcane. Leaves, stems, and culms of plants, especially rice grown in the presence of Si, show an erect growth, thereby the distribution of light within the canopy is greatly improved (Fig. 3) (11,12,42,57). Silicon increases rice resistance to lodging and drought and dry matter accumulation in cucumber and rice (1,12,40). Silicon can positively affect the activity of some enzymes involved in the photosynthesis in rice and turfgrass (57,58) as well as reduce the senescence of rice leaves (33). Silicon can lower the electrolyte leakage from rice leaves and, therefore, promote greater photosynthetic activity in plants grown under water deficit or heat stress (2). Silicon increases the oxidation power of rice roots, decreases injury caused by climate stress such as typhoons and cool summer damage in rice, alleviates freezing damage in sugarcane, favors supercooling of palm leaves, and increases tolerance to freezing stress in some plants (21,57). Silicon reduces the availability of toxic elements such as manganese, iron and aluminum to roots of plants such as rice and sugarcane and increases rice and barley resistance to salt stress (22,41,57).
Silicon and Rice Diseases: A Brief History
Probably, the first researcher who suggested that Si was involved in rice resistance to blast (Magnaporthe grisea (T. T. Hebert) Yaegashi & Udagawa) Barr (anamorph Pyricularia grisea (Cooke) Sacc.) was a Japanese plant nutrient chemist named Isenosuke Onodera. Onodera (46) published a milestone paper entitled ‘Chemical studies on rice blast disease’. This is the first report on Si research published in a scientific journal of agronomy. For this study, he collected rice plants from 13 different regions in western Japan. Onodera compared the chemical composition of the rice plants infected with blast with that of healthy ones grown in the same paddy field. He observed that diseased plants always contained less Si in comparison to healthy ones obtained from the same field, and that the natural Si content found in rice tissue depended on the paddy field in which the plants had been grown. His finding did not necessarily mean that blast infection was reduced by the Si content of the rice plants or that plants with less Si content were more susceptible. His results did show that there was a relationship between Si content and blast susceptibility. Although he did not intend to study the role of Si in rice resistance to blast, his discovery certainly stimulated further Si research in Japan.
Diseases Suppressed by Silicon Application
Kawashima (35) first demonstrated under controlled conditions that application of Si to rice plants increased resistance to blast as well as increased Si content in rice. The results showed that Si content in rice straw and husks were proportional to the amount of Si applied to the soil, and that the severity of blast on panicles was inversely proportional to the amount of the Si in rice tissues. Ito and Hayashi (29) and Miyake and Ikeda (44) also showed that the application of Si increased resistance to blast. Inokari, and Kubota (24) demonstrated that the application of Si to peat land paddy fields reduced the incidence of blast. Many other Japanese researchers demonstrated that applications of 1.5 to 2.0 tons/ha of various Si sources to Si-deficient paddy soils dramatically reduced the intensity of blast (65). Volk et al. (71) also reported that the number of blast lesions on leaves of Caloro rice cultivar decreased linearly as the Si content in leaf blades increased. Rabindra et al. (48) found that the content of Si in leaf and neck tissues varied among four rice cultivars grown under similar climatic conditions; and that those cultivars accumulating more Si in shoots showed less incidence of leaf and neck blast. Interestingly, the susceptibility to blast of some rice cultivars grown with different rates of Si was negatively correlated with the content of Si in the shoots (57). However, rice cultivars accumulating higher levels of Si in shoots are not always more resistant to blast than cultivars accumulating lower levels of Si when grown under the same cultural and environmental conditions (73).
| |

Fig. 4. Aerial photograph of rice fields in the Everglades Agricultural Area amended (A) or not amended (B) with calcium silicate. Note that the darker color of the untreated area in B is due to rice plants showing symptoms of both brown spot and blast. Reprinted from Crop Protection, Vol. 16, Datnoff, L. E., Deren, C. W., and Snyder, G. H., Silicon fertilization for disease management of rice in Florida, p. 526, 1997, with permission from Elsevier. |
Datnoff et al. (8) reported a significant reduction in severity of brown spot (Cochliobolus miyabeanus (Ito & Kuribayashi in Ito) Drechs. ex Dastur (anamorph Bipolaris oryzae (Breda de Haan) Shoemaker) and incidence of neck blast in rice plants growing in a Si-deficient Histosol in southern Florida following calcium silicate application. Rice plants showing symptoms of both brown spot and blast may display an overall darker color in contrast to silicon fertilized plants (Fig. 4). In 1987, applications of calcium silicate reduced neck blast by 30.5% and brown spot by 15.0% over the control (Fig. 5). In 1988, neck blast and brown spot were reduced by 17.4 and 32.4%, respectively, over the control (Figs. 6 and 7). The reduction in neck blast severity on rice panicles from plants amended with calcium silicate is quite apparent, visually (Fig. 8). In 1988, brown spot severity at the highest calcium silicate rate decreased 14.5, 17.6, and 16.5% over the control for residual 1987 calcium silicate effects on the 1988 rice crop, 1988 calcium silicate applications, and residual 1987 calcium silicate rates each receiving 5 Mg/ha of calcium silicate in 1988, respectively (Fig. 6). Others investigators have also reported a reduction in brown spot severity in response to Si application (18,40,45,69).
 |
|
 |
|
Fig. 5. Relationship of brown spot severity and neck blast incidence to rates of calcium silicate in 1987. |
|
Fig. 6. Relationship of brown spot severity to rates of calcium silicate in 1988. S87, calcium silicate applied only in 1987. S88, calcium silicate applied only in 1988. S87 + S88, 5 Mg/ha of calcium silicate applied in 1988 to each of the residual plots receiving the 1987 calcium silicate treatments. |
| |
 |
|
 |
|
| |
Fig. 7. Relationship of neck blast incidence to rates of calcium silicate in 1988. S87, calcium silicate applied only in 1987. S88, calcium silicate applied only in 1988. S87 + S88, 5 Mg/ha of calcium silicate applied in 1988 to each of the residual plots receiving the 1987 calcium silicate treatments. |
|
Fig. 8. Neck blast on rice panicles on the upland rice cultivar Oryzica 1 grown on soils amended (right) or not amended (left) with calcium silicate. |
|
Neck blast incidence at the highest calcium silicate rate decreased 29.1, 27.0, and 32.4% over the control for residual 1987 calcium silicate effects on the 1988 crop, 1988 calcium silicate applications, and residual 1987 calcium silicate rates each receiving 5 Mg/ha of calcium silicate in 1988, respectively (Fig. 7). Although the application of calcium silicate in 1988 suppressed neck blast more than the 1987 residual applications on the 1988 rice crop, the residual applications were still very effective. In rice straw samples from this study, only Si, not calcium (Ca), significantly increased over the control with increasing calcium silicate rates (Table 1), indicating that the reduction in neck blast severity can be accounted for only by increased levels of Si.
Table 1. Influence of various rates of calcium silicate on rice plant tissue calcium (Ca) and silicon (Si) content (dag/kg).
Slag rate
(Mg/ha) |
1997 |
1998 |
| S87a |
S88 |
S87+S88 |
| Ca |
Si |
Ca |
Si |
Ca |
Si |
Ca |
Si |
| 0 |
0.54 |
1.55 |
0.53 |
1.76 |
0.53 |
1.76 |
0.53 |
1.76 |
| 5 |
0.47 |
4.04 |
0.57 |
2.88 |
0.54 |
4.94 |
0.56 |
5.14 |
| 10 |
0.47 |
5.60 |
0.57 |
4.30 |
0.57 |
6.14 |
0.51 |
5.90 |
| 15 |
0.38 |
5.98 |
0.55 |
4.44 |
0.53 |
6.22 |
0.53 |
5.12 |
| FLSDb (P = 0.05) |
ns |
0.97 |
ns |
0.59 |
ns |
0.59 |
ns |
0.59 |
a S87 or S88 = calcium silicate applied at given treatment rates only in 1987 or 1988; S87+S8 = 5 Mg/ha of calcium silicate applied in 1988 to each of the residual plots receiving each of the 1987 treatments.
b FLSD = Fisher’s least significant difference value; ns = non-significant.
Grain discoloration, caused by a complex of fungal species such as Bipolaris oryzae, Curvularia sp., Phoma sp., Microdochium sp., Nigrospora sp., and Fusarium sp., is another important constraint for irrigated and upland rice production worldwide. Prabhu et al. (47) showed that the severity of grain discoloration in several irrigated and upland rice genotypes decreased linearly as the rates of SiO2 in the soil increased (Figs. 9 and 10). The severity of grain discoloration was reduced by 17.5%, on average, at the rate of 200 kg/ha of SiO2, while grain weight increased 20%.
 |
|
 |
|
Fig. 9. Effect of wollastonite (source of Si) on the severity of grain discoloration in Brazilian genotypes of rice grown under field conditions. Each data point represents the mean grain discoloration score of 48 genotypes. Source: Prabhu et al. (48). |
|
Fig. 10. Symptoms of grain discoloration on rice panicles of the rice cultivar BG 367-4 from (A) non-treated control plants (0 kg/ha of Si02) and (B) plants grown at the highest rate of Si02 (800 kg/ha). Photo from Dr. Anne S. Prabhu. |
Stem rot (Magnaporthe salvinii Cattaneo), leaf scald and sheath blight also have been efficiently suppressed by Si applications (11). Regarding bacterial diseases, Chang et al. (4), recently reported a significant reduction in lesion length of bacterial leaf blight (Xanthomonas oryzae pv. oryzae) of 5 to 22% among four rice cultivars following Si application. The reduction in lesion length was positively correlated with a decrease in the content of soluble sugar in leaves of plants amended with Si. Rice cultivars accumulating high levels of Si in roots also showed increased resistance to the root-knot nematode Meloidogyne spp. (67).
Silicon and Fungicides Interactions
Kitani and co-authors (37) probably were the first scientists to demonstrate the influence of Si and fungicides alone and in combination for controlling blast. In their study, Si applied as calcium silicate reduced neck blast severity almost as effectively as a mercuric fungicide, 12% versus 10% and 11.2% versus 7.4%, respectively, depending on the level of nitrogen applied (Table 2).
Table 2. Influence of calcium silicate and mercuric fungicide alone and in combination at two different nitrogen levels on% neck blast incidence and grain yield1.
| Treatments |
% Neck blast |
Grain weight (g/2.9 m2) |
| 50 kg/ha |
75 kg/ha |
50 kg/ha |
75 kg/ha |
| Silicon (Si)* |
12 |
11.2 |
1398.7 |
1415.7 |
| Fungicide (Fu)** |
10.1 |
7.4 |
1302.0 |
1357.3 |
| Si × Fu |
1.7 |
2.5 |
1425.0 |
1504.7 |
| Control |
26.5 |
42.5 |
1018.0 |
1012.7 |
1 Adapted from Kitani et.al. (1960).
* Calcium silicate applied at 2.25 ton/ha.
** Mercuric fungicide = phenyl mercuric acetate: calcium carbonate mixture (1:5) applied at 40 kg/ha.
Silicon alone was associated with a gain in grain weight over the control, 37% (N at 50 kg/ha) to 40% (N at 75 kg/ha). The mercuric fungicide application resulted in increased grain weights of 28% to 34%, for the two different N treatments. Combined Si/fungicide treatments were the most effective for the reduction of neck blast severity (below 3%) and increased grain weight (40% to 48%).
In Florida, an evaluation of Si fertilization in combination with the application of benomyl or propiconazole was undertaken to determine if Si could control diseases such as blast or brown spot as effectively as a fungicide (6,7). A rice crop was treated with Si at 0 and 2 Mg/ha and benomyl at 0 and 1.68 kg/ha and propiconazole at 0 and 0.44 liters/ha. Fungicide sprays were applied at panicle differentiation, boot, heading and heading plus 14 days. Blast incidence was 73% in the non-Si, non-fungicide control plots and 27% in the benomyl treated plots (Fig. 11). Where Si was applied, blast incidence was 36% in the non-fungicide plots and 13% in the benomyl treated plots (Fig. 11).
| |

Fig. 11. Influence of silicon fertilization and benomyl foliar spray on blast incidence. Values with the same letter are not significantly different based on Fisher’s LSD (P = 0.05). |
|
The same degree of blast control was generally obtained when either benomyl or Si were applied individually. Brown spot responses were similar to those observed with blast (Table 3; Fig. 12). Brown spot severity and disease progress were reduced to a greater extent by Si applications alone than with propiconazole applications. For both diseases, the greatest reduction in disease development was obtained by integrating Si fertilization with fungicides. Thus, Si provided control for two economically important diseases to a greater degree than current U.S. registered fungicides at the time these studies were conducted.
| |

Fig. 12. Symptoms of brown spot as influenced by applications of silicon (a and e), propiconazole (b), the combination of silicon + propiconazole (c), and the nontreated control (d). Reprinted from Crop Protection, Vol. 16, Datnoff, L. E., Deren, C. W., and Snyder, G. H., Silicon fertilization for disease management of rice in Florida, p. 529, 1997, with permission from Elsevier. |
|
Table 3. Effect of propiconazole and silicon on brown spot development.
| Treatment |
Lesion no. per cm2 |
AUDPCa |
Brown spot severityb |
| Control |
2.5 ac |
2772 a |
87 a |
| Propiconazole (P) |
2.0 b |
1124 b |
61 b |
| Silicon (Si) |
1.6 c |
583 c |
37 c |
| P+Si |
0.6 d |
284 d |
14 d |
a AUDPC = area under disease progress curve.
b Brown spot severity based on a 0 to 9 scale, where 0 = no disease and 9 = 76% or more of leaf area affected. The percent mean affected area of leaf for each numerical rating was used for estimating differences between treatments.
c Means followed by a different letter are significantly different based on FLSD (P = 0.05).
Reprinted from Crop Protection, Vol. 16, Datnoff, L. E., Deren, C. W., and Snyder, G. H., Silicon fertilization for disease management of rice in Florida, p. 528, 1997, with permission from Elsevier.
Considering that Si can control several diseases on rice to the same general degree as a fungicide, it is possible that Si might help reduce the number of fungicide applications or the rate of active ingredient used. This hypothesis was tested by Seebold (59) in field experiments on upland rice in the savannahs of Colombia. Silicon was applied as wollastonite at 400 kg of Si per ha, and the rice cultivar Oryzica Sabana 6 was seeded at 80 kg/ha. Treatments included a non-treated control, Si applied alone, and Si plus fungicides (edifenfos at 1 L/ha and tricyclazole at 300 g/ha) applied at the following growth stages: tillering (T), panicle initiation (PI), booting (B), 1% panicle emergence (1%), 50% panicle emergence (50%), PI, B, 1%, and 50%; B, 1% and 50%; 1% and 50%; B and 1%; PI and 1%; T (Fig. 13). Incidence of neck blast was significantly reduced using either Si alone or Si plus fungicides in comparison to the non-treated control (Fig. 13).
| |

Fig. 13. Effect of silicon and timing of fungicide applications on neck blast incidence. Fungicides timings are: tillering (T), panicle initiation (PI), booting (B), 1% heading (1%), 50% heading (50%) and various combinations. Stripe bars represent FLSD value (P = 0.05). |
|
Silicon alone significantly reduced incidence of neck blast by 40%. The treatment of Si plus one fungicide application reduced neck blast 75 to 90%, while Si plus two applications reduced neck blast 76 to 94%. Silicon plus three to five applications reduced neck blast 94 to 98%. No significant differences in yield were observed among Si alone or Si plus fungicide applications, regardless of timing, with all treatments significantly increasing yield in comparison to the control.
In another experiment, Si was incorporated prior to seeding at 0 and 1000 kg/ha (61). Two foliar applications of edifenfos were applied at 0, 10, 25 and 100% of recommended rates. Ratings of leaf blast for Si alone and Si plus edifenfos at various rates were 54 to 75% lower than in the non-treated control (Table 4).
Table 4. Effects of silicon and fungicides alone and in combination on area under leaf blast progress curve (AULBPC), neck blast incidence, and rough rice yields.
Si
(kg/ha)a |
Fungicideb
rates (%) |
AULBPC |
Neck blast
incidence (%) |
Yield
(kg/ha) |
| 0 |
0 |
4.3 ac |
72 a |
2284 d |
| 10 |
1.8 cd |
26 c |
2769 cd |
| 25 |
2.9 d |
20 cd |
2777 cd |
| 100 |
2.7 b |
12 ef |
2932 bc |
| 1000 |
0 |
1.6 cd |
44 b |
3445 a |
| 10 |
1.4 d |
18 de |
3373 ab |
| 20 |
2.2 bc |
15 de |
3682 a |
| 100 |
1.4 d |
6 f |
3380 ab |
a Silicon applied as calcium silicate at 5 ton/ha = 1000 kg of Si per ha.
b Fungicides applied as 10, 25 and 100% of recommended rate. Edifenfos applied for leaf blast and tricyclazole applied for neck blast.
c Means followed by same letter are not significantly different based on Fisher’s LSD.
For neck blast, Si alone and Si plus edifenfos and tricyclazole at various rates were 28 to 66% lower in comparisons to the non-treated control. The greatest reductions in leaf and neck blast were observed where Si plus the full rate of fungicide had been applied. Silicon plus lower rates of fungicides (10 and 25%) were able to reduce leaf and neck blast as effectively as a full rate of the fungicide. Silicon alone was just as effective as the fungicides alone, in comparison to the check treatment, for reducing leaf blast severity and promoting plant growth (Fig. 14).
| |

Fig. 14. Overall symptoms of blast on the lower leaves of the rice cultivar Oryzica 1 for the non-amended control (A) in comparison to plants amended with Si (B) or treated with fungicides (C). Note the clear difference in plant vigor between the non-amended control and the treatments receiving either Si or fungicides. |
|
Fungicides improved yields by 22 to 28% over the control. Interestingly, Si alone improved yields by 51%, and this increase was significantly greater than the fungicide contribution. The effect of Si on reducing a disease such as blast unquestionably contributed to an increase in yield, but Si also has been shown to increase yields in the absence of disease (56). Increase in grain yield can be attributed to an increase in the number of grains per panicle (10). Spikelet fertility also has been associated with Si concentration in rice (56). Therefore, Si alone could improve grain yields of rice cultivars without further genetic improvements.
In 1995 and 1996 experiments, Si was incorporated prior to seeding at 0 and 1000 kg/ha (80). Plots that were treated in 1995 (residual Si) were compared to plots receiving a fresh or current year application of Si in 1996 to study the residual effect. Two foliar applications of edifenfos, sprayed at 20 and 35 days after planting, were made and followed by three applications of tricyclazole. Leaf blast was evaluated as percent area of individual leaves and neck blast was rated as percent incidence of 100 panicles. In both 1995 and 1996, ratings of leaf blast for Si alone (residual and fresh applications) and Si plus edifenfos (residual and fresh applications) were 50 to 68% lower than those in the the non-treated control plots (Table 5).
Table 5. Comparisons made in 1996 of area under leaf blast progress curve (AULBPC), incidence of neck blast and yields from rice treated with silicon (Si) in 1995 (residual) with either fresh Si applications in 1996, fungicidea alone, or fungicides in combination with Si.
| Treatments |
AULBPC |
Neck blast
(%) |
Yield
(kg/ha) |
Residual Si-1995 application
(1000 kg/ha)b |
2.2 |
43 |
3042 |
| Non-treated control 1996 |
4.3 (0.0001)c |
72 (0.0001) |
2284 (0.0004) |
| Fresh Si-1996 application |
2.0 (0.08) |
44 (0.60) |
3444 (0.04) |
| Fungicides alone 1996 |
2.7 (0.08) |
12 (0.0001) |
2932 (0.57) |
Residual (1995 Si application)
+ fungicides 1996 |
1.8 (0.37) |
9 (0.0001) |
3101 (0.77) |
Fresh Si (1996 application)
+ fungicides 1996 |
1.4 (0.01) |
6 (0.0001) |
3380 (0.09) |
a Fungicides = edifenfos applied for leaf blast and tricyclazole applied for neck blast.
b Comparisons are made between the residual Si-1995 application (1000 kg/ha) with the other five treatments for AULBPC, neck blast, and yield.
c Number in parentheses are P values from comparison between AULBPC, neck blast, and yield for residual Si application in 1995 and 1996 treatments. Means are considered to be significantly different if P < 0.05 based on t-tests of two means in each comparison.
The greatest reductions in leaf blast were observed where both Si and a fungicide had been applied. The one year residual Si application was as effective as a fresh application, and these treatments were not significantly different for leaf blast control in comparison to edifenfos alone or in combination with a one year residual. Silicon alone reduced leaf blast to the same level as the edifenfos applied with Si in 1995. In 1996, ratings of leaf blast for Si alone were significantly lower (35%) than for the full rate of fungicide. Incidence of neck blast was reduced 28 to 66% with applications of Si and Si plus tricyclazole (Table 5). A one year residual application of Si applied in 1995 was as effective as a fresh application in 1996 in reducing neck blast incidence. However, these treatments were not as effective as a fungicide applied alone or in combination with Si. The fungicide tricyclazole applied alone or in combination with Si resulted in the largest reductions in neck blast incidence. Silicon alone and in combination with tricyclazole applied in 1995 or in 1996 increased yields 28 to 51% over the non-treated control (Table 5). The 1995 residual Si application was as effective in increasing yields and not significantly different from tricyclazole alone or tricyclazole applied in combination with Si applied in 1995 or 1996.
In conclusion, the authors noted that Si can control diseases as effectively as fungicides. Silicon apparently can help to reduce the number of fungicides applied in a growing season. The use of Si plus reduced rates of fungicides are as effective as full rates of fungicides alone. These results suggest that the number of fungicide applications and their rates may be reduced. A one year residual application also is effective for reducing leaf and neck blast and maintaining rice yields. Since Si alone enhanced yields more effectively than fungicides alone, fungicides might be eliminated altogether. Consequently, growers may save either initial or additional application costs for either fungicides or Si while providing positive environmental benefits.
Effects of Silicon on Components of Host Resistance
Seebold et al. (62) evaluated the effects of Si on several components of resistance in four rice cultivars with different levels of resistance to race IB-49 of M. grisea grown in Si-deficient soil amended with Si at 0, 2, 5, and 10 tons/ha. The cultivar M201 has no known major or minor genes for resistance to race IB-49 of M. grisea and is completely susceptible. The cultivars Rosemont and Lemont are partially resistant and the cultivar Katy is completely resistant. For each cultivar tested, the incubation period was lengthened by increased rates of Si, while lesion length, rate of lesion expansion, and disease leaf area were dramatically decreased.
Relative infection efficiency of M. grisea, determined as the number of sporulating lesions per square millimeter of leaf area, was highest on M201 and Rosemont and lowest on Katy (Fig. 15a). The relationship between number of sporulating lesions per leaf area and rate of calcium silicate was linear for all cultivars (Fig. 15b).
| |

Fig. 15. Effects of calcium silicate on the number of sporulating lesions of blast (relative infection efficiency) for rice cultivars M201, Rosemont, Lemont, and Katy. A, Mean number of sporulating lesions per square millimeter of leaf for each cultivar averaged across rate of calcium silicate. Bars with the same letter in A do not differ significantly at P = 0.05 as determined by Fisher’s protected LSD test performed on log-transformed values. B, The relationship between the number of sporulating lesions per square millimeter of leaf and rate of calcium silicate, averaged across means for all cultivars. C, The number of sporulating lesions per square millimeter of leaf for each cultivar and rate of calcium silicate. Bars represent standard errors of means. |
|
The cultivar Lemont had 92% fewer sporulating lesions per leaf area than M201. Relative infection efficiency was 97% lower on Katy compared with M201 and was significantly lower when compared with Rosemont or Lemont, except at the highest rate of Si. The number of sporulating lesions counted on Lemont treated with 10 tons of calcium silicate per ha was not significantly different from the number occurring on Katy, but there was no significant change in the number of sporulating lesions on Katy at any rate of calcium silicate (Fig. 15C). When the rate of calcium silicate was increased from 0 to 10 ton/ha, the number of sporulating lesions per leaf area decreased by 71% on M201, Rosemont, and Lemont (Fig. 15B and C). By reducing relative infection efficiency, the number of sporulating lesions that can contribute inoculum for secondary cycles is curtailed. In addition, reductions in size of lesions further limit inoculum production. The effect of Si on this component of resistance was more apparent on partially resistant or susceptible cultivars and was rate-responsive. In the case of blast-resistant Katy, the number of sporulating lesions found on plants that did not receive calcium silicate was near zero. Osuna-Canizales et al. (47) also found no differences in the number of sporulating lesions between resistant cultivars grown in a solution containing Si and those that had not received Si.
The number of spores per square millimeter of lesion was different among all four cultivars (Fig. 16A). Sporulation per square millimeter of lesion was over three times higher on M201 than on Rosemont and 10 times higher than that seen on Lemont. The relationship between rate of calcium silicate and the number of spores per square millimeter of lesion was linear for all cultivars, but significant only at P = 0.10 (Fig. 16B). Sporulation per square millimeter of lesion on all cultivars was reduced by 47% as the rate of calcium silicate increased from 0 to 10 ton/ha. Only M201 showed a decreased in spores per square millimeter of lesion as the rate of Si increased. The effect of Si on the number of conidia per lesion was not clear. Although a general decline in number of conidia was observed across all cultivars, an examination of means by cultivar shows that, in reality, sporulation per lesion area was reduced by Si on M201 only.
| |

Fig. 16. Effects of calcium silicate on the sporulation of blast lesions for cultivars M201, Rosemont, Lemont, and Katy. A, The number of spores per square millimeter of lesion for each cultivar averaged across rates of calcium silicate. Bars with the same letter do not differ significantly at P = 0.05 as determined by Fisher’s protected LSD test performed on log-transformed values. B, The relationship between the number of spores per square millimeter of lesion and rate of calcium silicate averaged across means for all cultivars. |
|
Despite having nearly the same content of Si in leaf tissue as M201, no change in sporulation occurred on Rosemont or Lemont at 0, 5, and 10 ton of calcium silicate per hectare, and no conidia were recovered from lesions on Katy. It is important to note that the total number of lesions available for estimating the number of conidia was smaller on the partially resistant and resistant cultivars than on the susceptible cultivar, and the number decreased as the rate of Si increased. Thus, the small sample sizes and inherent resistance in some cultivars contributed to erratic estimates of the number of conidia per square millimeter of lesion. In the case of Katy, sporulating lesions were rare at any rate of Si. Sporulation per lesion is probably of less epidemiological importance than the reduction in lesion number.
Regardless of the rate of Si, the daily rate of lesion expansion was significantly higher on M201 than on Rosemont, Lemont, or Katy (Fig. 17A). Rate of lesion expansion was 42 and 59% slower on Rosemont and Lemont, respectively, compared with M201 and did not differ significantly between these two cultivars. Rate of lesion expansion was slower on Katy than on Rosemont, Lemont, or M201 (Fig. 17A). For all cultivars, rate of lesion expansion decreased from 0.8 to 0.43 mm per day (49%) as the rate of calcium silicate increased from 0 to 10 ton/ha (P < 0.07) (Fig. 17B). The effect of Si rate on lesion length was less significant than for relative infection efficiency. Unlike relative infection efficiency, lesion length was reduced on all cultivars by an average of 46% with increasing rates of Si. Therefore, the mechanism by which Si acts to reduce lesion size appears to compliment the resistance to blast expressed by the cultivars tested in this study. The rate of lesion expansion was closely associated with the length of lesions. Lesions caused by M. grisea are determinate in size and reached maximum size at roughly the same time for all cultivars and rates of Si, resulting in measurements similar to those for length of lesion. Of these two components, lesion length appears to be a more important component of resistance to leaf blast than rate of lesion expansion because sporulation was not observed on lesions from any treatment until maximum size was reached. Similar observations were made for sheath blight development by Rodrigues and his colleagues (54).
| |

Fig. 17. Effects of calcium silicate on the daily rate of expansion of blast lesions for rice cultivars M201, Rosemont, Lemont, and Katy. A, The rate of expansion of blast lesions for each cultivar averaged across rates of calcium silicate. Bars with the same letter do not differ significantly at P = 0.05 as determined by Fisher’s protected LSD test. B, The relationship between rate of lesion expansion and rate of calcium silicate, averaged across means for all cultivars. |
|
Possible Mechanisms for Silicon-mediated Rice Resistance
In the rice-M. grisea pathosystem, increased resistance through Si treatment has been associated with the density of silicified buliform, long, and short cells in the leaf epidermis that act as a physical barrier to impede penetration by M. grisea (20,29,66). This physical barrier hypothesis is strengthened by the findings of Yoshida et al. (76), who reported the existence of a layer of silica of approximately 2.5 µm thick beneath the cuticle of rice leaves and sheaths. This cuticle-Si double layer can impede M. grisea penetration and, consequently, decrease the number of blast lesions on leaf blades. According to Volk et al. (71), Si might form complexes with organic compounds in the cell walls of epidermal cells, therefore increasing their resistance to degradation by enzymes released by M. grisea. Indeed, Si can be associated with lignin-carbohydrate complexes in the cell wall of rice epidermal cells (23).
Kim et al. (36) investigated some of the cytological features of Si-mediated resistance to blast. The authors observed that the epidermal cell wall thickness was not significantly affected by Si. However, the thickness ratios of silica layers to epidermal cell walls were much higher in the resistant cultivar than in the susceptible cultivar. Although the fortification of epidermal cell walls was considered the main cause for the reduced number of leaf blast lesions, no evidence was given to indicate that the penetration peg of M. grisea did not overcome the physical impedance offered by the fortified cell wall. Interestingly, Ito and Sakamoto (30) studied the puncture resistance of rice epidermal cells to a needle tip from beneath a torsion balance using leaves collected from rice plants grown under different Si rates. Their results showed that the puncture resistance was not explained solely by the leaf epidermis silicification; rather, it was attributed mainly to the nature of the protoplasm of epidermal cells. In another study, it was reported that rice cultivars resistant to blast had lower lesion numbers and silicified epidermal cells than susceptible cultivars (34). As reported by Hashioka (19), the density of silicified cells in rice leaf epidermis is not always proportional to the level of resistance of some rice cultivars to blast. Altogether, these observations suggest that resistance of Si-treated plants to M. grisea is much more complex than a physical resistance against penetration due to the silicified cells or to the cuticle-Si double layer.
Seebold et al. (62) made some inferences about the mechanisms by which Si acts to reduce blast. The authors noted that the reduced number of sporulating lesions (relative infection efficiency) on partially resistant and susceptible cultivars fertilized with calcium silicate indicated there were fewer successful infections established per unit of inoculum, lending support to the physical barrier hypothesis. The reductions in the total number of lesions as the rates of Si increased clearly indicated that Si manifested its effect before the penetration peg of M. grisea actually entered the epidermis, or soon thereafter, indicative of blockage to ingress by the fungus.
In an attempt to gain further insight into the role of Si in rice blast resistance, Rodrigues et al. (50) investigated the ultrastructural outcome of the rice-M. grisea interaction upon Si application. The authors provided the first cytological evidence that Si-mediated resistance to M. grisea in rice correlated with a specific leaf cell reaction that interfered with the development of M. grisea. After inoculation with M. grisea, ultrastructural observations of samples collected from plants not amended with Si revealed that some host cells were devoid of organelles and that some host cell walls were no longer discernible in the massively colonized mesophyll and vascular bundle (Fig. 18A and B). A light deposition of osmiophilic material with a granular texture, occasionally interacting with fungal walls, was seen in some epidermal cells (Fig. 18C, arrows). In plants amended with Si, empty fungal hyphae were evenly surrounded by a dense layer of granular osmiophilic material partially occluding the epidermal cells (Fig. 18D, arrows), the vascular bundle (Fig. 18E, arrowheads), and the mesophyll cells (Fig. 18F, arrows). The possibility that this amorphous material contains phenolic compounds appears realistic, considering not only its staining with toluidine blue and its texture and osmiophilic properties, but also the occurrence of marked fungal hyphae alterations. Cytochemical labeling of chitin revealed no difference in the pattern of chitin localization over fungal cell walls of either samples from plants amended or not with Si at 96 h after inoculation with M. grisea indicating limited production of chitinases as one mechanism of rice defense response to blast. On the other hand, the occurrence of empty fungal hyphae, surrounded or trapped in amorphous material, in samples from plants amended with Si suggested that phenolic-like compounds or phytoalexin(s) played a crucial role in rice defense response against infection by M. grisea. Therefore, Si could be acting as a modulator to positively amplify rice defense response(s), namely by influencing the synthesis of antifungal compounds after the penetration peg of M. grisea enters the epidermal cell.
| |
 |
|
| |
Fig. 18. Transmission electron micrographs of leaf samples collected from Si– and Si+ rice plants 96 h after inoculation with Magnaporthe grisea. A, Ultrastructurally normal fungal hyphae colonize both the epidermis and mesophyll. Host cell walls are no longer discernible in the mesophyll (Si–). Bar = 2 µm. B, The vascular bundle is massively colonized by the fungal hyphae (Si–). Bar = 5 µm. C, Some amorphous material (arrows) accumulates in an epidermal cell and irregularly interacts with a fungal cell wall (Si–). Bar = 1 µm. D, A dense amorphous material (arrows) accumulates around an empty fungal hyphae in the epidermal cell and also is found in an epidermal cell neighboring the colonized one (Si+). Bar = 1 µm. E, Fungal hyphae invading the vascular bundle are often surrounded by dense amorphous material and often reduced to empty shells (Si+; arrowheads). Bar = 2 µm. F, Two fungal hyphae in a mesophyll cell are evenly coated by the amorphous material (Si+; arrows) Bar = 1 µm. Amorphous material (AM), fungal hyphae (F), epidermis (E), mesophyll (M), host cell wall (HCW), and vascular bundle (V). |
|
In a further study, Rodrigues et al. (53) tested the hypothesis that an alteration in the development of M. grisea in leaf tissues of rice plants amended with Si could be associated with an enhanced production of phytoalexin(s). Analysis of the ethyl ether fraction (FII) obtained from leaf extracts of plants amended with (Si+) or without (Si-) and inoculated with M. grisea revealed that of the five sub-fractions (SF) collected, only SF5, which corresponded to compounds eluting after 90 min in the HPLC chromatograms, displayed antifungal activity against M. grisea (Fig. 19). The SF5 from Si+ treatment showed higher fungitoxicity against M. grisea than SF5 from Si- treatment. Sub-fractions 1, 2, 3, and 4 had no apparent antifungal activity against M. grisea regardless of Si treatment.
| |
Fig. 19. Bioassay of the fungitoxic activity of sub-fraction (SF) five (the most apolar sub-fraction from FII) against M. grisea. The SF5 was obtained from the ethyl ether fraction (FII) of leaf extracts from plants amended with (Si+) or without (Si- ) silicon and inoculated with M. grisea. Growth of M. grisea was monitored daily in the four treatments until the two fungal colonies reached confluence in the control (150 µl of methanol). The confluence occurred at approximately 120 hours after the agar plugs containing the fungus were transferred to the plates. Note a difference in the radial growth of M. grisea especially in the area immediately surrounding the well. |
|
|
|
Based on these observations, SF5 from FII was further analyzed by HPLC. This allowed separation of the two momilactones on the basis of their ultraviolet spectra and retention time (Rt) (momilactone A Rt 46 min and momilactone B Rt 47 min). These compounds were present in small quantities in non-inoculated plants amended or not with Si (Fig. 20A and B). By contrast, both products were present at 2 to 3 time the concentration in leaf extract from plants amended with Si and inoculated with M. grisea treatment (Fig. 20D) compared to the lower levels observed in leaf extract from inoculated plants non-amended with Si (Fig. 20C).
| |
 |
|
Fig. 20. High-performance liquid chromatography analysis of sub-fraction 5 (the most apolar sub-fraction) obtained from the ethyl ether fraction (FII). A, Non-inoculated plants not amended with silicon (Si- M. grisea -). B, Non-inoculated plants amended with silicon (Si+ M. grisea -). C, Plants not amended with silicon and inoculated with Magnaporthe grisea (Si- M. grisea+). D, Plants amended with silicon and inoculated with M. grisea (Si+ M. grisea+). Note the presence of two peaks in leaf extracts from Si+ M. grisea- and Si- M. grisea+ treatments which reached much higher quantities in the Si+ M. grisea+ treatment. These two peaks correspond to momilactones A and B based on their ultraviolet spectra (l max 212 nm) and retention times (momilactone A Rt 46 min and momilactone B Rt 47 min). |
|

Fig. 21. Development of leaf blast symptoms at 96 h after inoculation with Magnaporthe grisea in rice plants nonamended (-Si) or amended with (+Si) with silicon. |
|
Rice plants not amended with Si and inoculated with M. grisea, in spite of releasing antifungal compounds including momilactones, were obviously not protected efficiently against fungal colonization. By contrast, rice plants amended with Si and inoculated with M. grisea, releasing higher amounts of momilactones probably earlier in the infection process, benefited from a lower level of rice blast severity (Fig. 21).
While little is known about the mechanism(s) of resistance of rice plants amended with Si in response to M. grisea infection, two mutually agreeable hypotheses must be considered. On the one hand, it is possible that in certain areas of heavy Si deposition, delayed fungal ingress and colonization provides the rice plant enough time for momilactones, synthesized in response to infection by M. grisea, to accumulate to considerable levels and express their fungitoxicity within the zone of the infection site. On the other hand, as proposed by Fawe et al. (15), the soluble Si present in the plant cells may mediate some defense responses that are functionally similar to systemic acquired resistance. The results of this study, together with the ultrastructural observations, strongly suggest that Si plays an active role in the resistance of rice to blast rather than simply forming a physical barrier in leaf epidermis to impede fungal penetration.
The Economic Potential of Silicon for Sustainable Rice Production
Prolific Si research on a variety of issues such as disease suppression and yield gains has not included any economic analysis. Perhaps for that reason, despite all the potential beneficial effects, most Si sources are considered to be too expensive. Alvarez and Datnoff (3) conducted a benefit/cost analysis (partial budgeting) to investigate the possibility that the numerous benefits obtained from Si applications could outweigh the costs of the material and application in some regions of the world.
Benefits and costs. In order to quantify benefits and costs for the base case from a wide range of data resulting from the field studies above, it is necessary to make some preliminary general assumptions as follows:
(a) Application rate: 2.5 ton/ha of calcium silicate slag (standard Si grade from Calcium Silicate Corporation, Inc., Lake Harbor, FL), with a 22% Si content or 500 kg/ha of elemental silicon, at a cost of $48/ton including application, with a length of effectiveness of two years.
(b) Average yield: 5,000 kg/ha without Si application. Costs and prices were obtained in Florida from a rice mill in the Everglades Agricultural Area and dealers servicing the local producers in early 1998. Once an upper limit is obtained from these assumptions, a sensitivity analysis was conducted to reflect lower benefits in other regions of the world.
Impact on rice yields. The review of the literature conducted by Savant et al. (57) found several levels of yield increases ranging from 10% to 30%. In another study, yields were raised by more than 500 kg/ha. Other results showed increases ranging from 4.6% to 20.7%, and a 48% boost was reported in another study. A 12% increase in yields translates into 600 kg/ha. If the price of U.S. No. 2 rough rice is $0.24/kg, the extra gross revenue amounts to $144/ha. Silicon cost is $120/ha; the cost of harvesting and hauling the extra rice produced is $0.0046/kg or $2.76/ha ($0.0046 × 600), subsequently, the first year extra net revenue amounts to $21.24/ha ($144 - $120 - $2.76). Calculation of the extra net revenue for the second year requires the use of the present value formula: $1(1+i)-n = $1(1+0.08)-1.5 = 0.891; where i = interest rate (8%) for discounting income, and n = number of years (1.5) until income is received; or ($144 - $2.76) × 0.891 = $125.84/ha. Thus, the average extra net revenue per year amounts to $73.54/ha (Table 6). This figure appears to be an upper limit because of the associated economic conditions prevalent in the United States.
Table 6. Assumptions and resulting economic benefits from yield increases due to silicon applications in the base case and two alternate cases.
| Assumptions |
Base
case |
Alternate
case 1 |
Alternate
case 2 |
| Average yield w/o silicon (kg/ha) |
5,000 |
2,500 |
7,500 |
| Application rate (ton/ha) |
2.5 |
2.0 |
3.0 |
| Yield increase (%) |
12 |
30 |
8 |
| Silicon cost ($/ton) |
48 |
48 |
48 |
| Extra production cost ($/kg) |
0.0046 |
0.005 |
0.005 |
| Price of rice ($/kg) |
0.24 |
0.15 |
0.15 |
| Interest rate for discounting income (%) |
8 |
12 |
16 |
| Extra net revenue ($/ha/year) |
73.54 |
52.32 |
6.43 |
Some of the above assumptions are changed for two alternate cases that could occur in other countries: In alternate case 1, the average yield is 2,500 kg/ha, and the potential yield increase is set at 30% after application of Si at a rate of 2.0 ton/ha. Because of high variability, which depends on the availability of local sources, the cost of the material remains the same. Extra production costs are somewhat higher ($0.005/kg), as well as the interest rate for discounting income (12%). The price of rice is set at $0.15/kg, or 9 cents lower than in the base case. The average annual extra net revenue in this case amounts to $52.32/ha (Table 6).
Alternate case 2 intends to portray the case of much higher yields in some areas. The initial yield level is set at 7,500 kg/ha, and the corresponding application rate to 3.0 ton/ha to achieve an 8% increase in yields. The cost of Si, the extra cost of production, and the price of rice remain as in the alternate case 1, but the interest rate for discounting income is increased to 16% to reflect higher interest rates in some countries. The extra net revenue per year amounts to only $6.43 (Table 6).
Other benefits and costs combined: the base case. This section duplicates what was done with yield increases but combining all other potential benefits from Si applications. In addition to the base case, alternative cases 1 and 2 are also discussed (Table 7).
Table 7. Potential benefits ($/ha/year), other than yield increases, due to silicon applications in the base case and two alternate cases.
| Potential benefits |
Base
case |
Alternate
case 1 |
Alternate
case 2 |
| Controlling blast and other diseases |
74.69 |
37.34 |
0.00 |
| Grain discoloration |
61.60 |
30.80 |
30.80 |
| Insect management |
21.00 |
10.50 |
10.50 |
| Reducing phosphorus applications |
12.75 |
6.37 |
8.92 |
| Eliminating lime applications |
101.81 |
50.90 |
0.00 |
| Extra net revenue ($/ha/year) |
271.85 |
135.91 |
50.22 |
Disease management. (a) Controlling blast and other diseases. It has been demonstrated that silicon may eliminate the need for fungicides in managing rice diseases (61). Following the same price-cost structure defined above for the base case, the savings from two applications of fungicide per year, including cost of material and application, are $79/ha. The second year savings are $70.39 ($79 × 0.891). Thus, average annual savings are $74.69/ha (Table 7). (b) Potential grain discoloration. Research has shown that Si application, in addition to a healthier plant, also results in better grain appearance (48,60). In Florida, it is widely recognized that silicon improves the quality of the rice grain, which translates into better grain milling and an increase in its white color. In countries with strict grades and standards, this result provides a definite market advantage to producers. The penalty for moving from U.S. No. 2 to U.S. No. 3 rice as a result of grain discoloration in the United States is $0.011/kg at the reference price. If the quality increases from No. 3 to No. 2 due to the Si application, the 5,600 kg/ha previously estimated generate an added annual net income of $61.60/ha (Table 7).
Insect management. Silicon has the ability to considerably reduce several economically important insect pests. That fact leads to a reduction in insecticide applications. For example, if the cost of one application is $10.50/ha, and they are reduced from three to one per crop (57), total savings amount to $21/ha (Table 7).
Fertility management. (a) Reducing phosphorus applications. In upland conditions, P applications may be reduced every year (16). For example, if 25 kg/ha need to be applied instead of 50 kg/ha, and the cost of P2O5, including application, is $0.51/kg, total annual savings per crop amount to $12.75/ha (Table 12). (b) Eliminating lime applications. In acid soils where the application of Si eliminates or reduces the need for liming, more savings can be obtained (11). Assume the cost of applying dolomitic lime to one hectare at $5.25, and 3.60 mt/ha were applied at a cost of $26.67 mt before using Si. If liming is completely suppressed, the annual savings amount to $101.81/ha (Table 7).
Other benefits and costs combined: the alternate cases. The results from the basic case changed dramatically when we changed the assumptions in the two alternate cases. In alternate case 1, we just divided by two the potential benefits in the base case. This reflects the same cost-price structure used in the base case but was done to account for those potential benefits at half the scale. Alternate case 2 leaves intact the results concerning grain discoloration and insect management in alternate case 1. It also assumes that P applications are only 7% of the base case. In addition, it assumes no fungicide and lime applications. These assumptions intend to portray the Asian situation, where most of the rice is actually grown. The resulting extra net revenues per year in alternate case 1 are $135.91, and $50.22 in alternate case 2.
Total benefits and conclusions. The Table 6 provides a range of net benefits from yield increases, while Table 7 does that from other benefits resulting from Si applications. Comparing the two extremes in both tables gives an idea of the potential magnitude of those benefits. The highest figures in both tables represent the base case. They amount to extra net revenues of $345.39/ha/year. The lowest figures in both tables portray alternate case 2 and add up to additional net revenues $56.65/ha/year due to Si applications. It is difficult to apply the cost of Si, including application, in other countries of the world, and relate them to the benefits described above including the monetary savings and the use of available land for the production of other crops. When all benefits are considered, it is not unreasonable to believe that they outweigh the cost of Si, including application, in some rice-producing countries of the world.
Outlook and Future Silicon Research Needs
Silicon fertilization of rice grown in soil orders with Si levels less than optimal offers promising results with respect to reduced rice susceptibility to diseases and improved yields. Interestingly, Si can control rice diseases to the same general degree as is typically obtained by using fungicide applications and also contributes to reducing the amount of fungicides needed. Consequently, sources of Si and their management practices should be developed and practiced in integrated pest management programs for those crops where Si has been demonstrated to have a positive effect.
Some Si sources have residual activity that persists over time, raising the possibility that applications need not be made annually. Also, after the first initial Si amendment, subsequent application rate requirements might be considerably lower due to these residual effects. However, silicate slags are considered to be expensive Si sources so there is a need to find or develop cheaper and more efficient sources of Si. Recycling of rice hulls and/or straw may be one possible alternative.
Rice genotypes may differ in their Si content, and or respond differently to Si application. Genetics definitely plays an important role in Si accumulation and merits further consideration while selecting genotypes for other important agronomic traits. The strategic combination of a fine-grade Si formulation with a ‘Si-accumulator’ cultivar/genotype also would reduce application rate requirements, thereby minimizing the cost of the Si amendment program.
The fact that Si plays an important role in the mineral nutrition of many plant species is not in doubt nor is its ability to efficiently control several plant diseases. Effective, practical means of application and affordable sources of Si are needed for use in row crop agriculture in particular. As the need for environmentally friendly strategies for management of plant diseases increases, Si could provide a valuable tool for use in crops capable of its accumulation. The use of Si for controlling plant diseases would be well-suited for inclusion in integrated pest management strategies and would permit reductions in fungicide use. As researchers and growers become aware of Si and its potential in agriculture, it is likely that this often overlooked element will be recognized as a viable means of sustainably managing important plant diseases worldwide.
Literature Cited
1. Adatia, M. H., and Besford, A. T. 1986. The effects of silicon on cucumber plants grown in recirculating nutrient solution. Annals of Botany 58:343-351.
2. Agarie, S., Agata, W., and Kaufman, P. B. 1998. Involvement of silicon in the senescence of rice leaves. Plant Prod. Sci. 1:104-105.
3. Alvarez, J., and Datnoff, L. E. 2001. The economic potential of silicon for integrated management and sustainable rice production. Crop. Prot. 20:43-48.
4. Chang, S. J., Tzeng, D. D. S., and Li, C. C. 2002. Effect of silicon nutrient on bacterial blight resistance of rice (Oryza sativa L.). Pages 31-33 in: Second Silicon in Agriculture Conference. T. Matoh, ed. Press-Net, Kyoto, Japan.
5. Correa-Victoria, F. J., Datnoff, L. E., Okada, K., Friesen, D. K., Sanz, J. I., and Snyder, G. H. 2001. Effects of silicon fertilization on disease development and yields of rice in Colombia. Pages 313-322 in: Silicon in Agriculture. L. E. Datnoff, G. H. Snyder, and G. H. Korndörfer, eds. Studies in Plant Science, Vol. 8. Elsevier Science B. V., Amsterdam, The Netherlands.
6. Datnoff, L. E., and Snyder, G. H. 1994. Comparison of silicon and benomyl alone and in combination for reducing blast incidence. Biol. Cult. Tests Control Plant Dis. 9:113.
7. Datnoff, L. E., Deren, C. W., and Snyder, G. H. 1997. Silicon fertilization for disease management of rice in Florida. Crop Prot. 16:525-531.
8. Datnoff, L. E., Snyder, G. H., Raid, R. N., and Jones, D. B. 1991. Effect of calcium silicate on blast and brown spot intensities and yields of rice. Plant Dis. 75:729-732.
9. Datnoff, L. E., Victoria-Correa, F. J., Seebold, K. W., and Snyder, G. H. 2000. Silicon management of blast in upland and irrigated rice ecosystems. Pages 180-187 in: Advances in Rice Blast Research. D. Tharreau, M. H. Lebrun, N. J. Talbot, and J. L. Notteghem, Eds., Kluwer Academic Publishers, The Netherlands.
10. Deren, C. W., Datnoff, L. E., Snyder, G. H. and Martin, F. G. 1994. Silicon concentration, disease response, and yield components of rice genotypes grown on flooded organic Histosols. Crop Sci. 34:733-737.
11. Elawad, S. H., and Green, V. E. 1979. Silicon and the rice plant environment: A review of recent research. Riv. Riso 28:235-253.
12. Epstein, E. 1991. The anomaly of silicon in plant biology. Proc. Natl. Acad. Sci. USA 91:11-17.
13. Epstein, E. 1999. Silicon. Annu. Rev. Plant Physiol. Plant Mol. Biol. 50:641-664.
14. Fawe, A., Abou-Zaid, M., Menzies, J. G., and Bélanger, R. R. 1998. Silicon-mediated accumulation of flavonoid phytoalexins in cucumber. Phytopathology 88:396-401.
15. Fawe, A., Menzies, J. G., Chérif, M., and Bélanger, R. R. 2001. Silicon and disease resistance in dicotyledons. Pages 159-169 in: Silicon in Agriculture. L. E. Datnoff, G. H. Snyder, and G. H. Korndörfer, eds., Elsevier Science, New York, NY.
16. Foy, C. D. 1992. Soil chemical factors limiting plant root growth. Adv. Soil Sci. 19:97-149.
17. Friesen, D. K., Sanz, J. I., Correa, F. J., Winslow, M. D., Okada, K., Datnoff, L. E., and Snyder, G. H. 1994. Silicon deficiency of upland rice on highly weathered Savanna soils in Colombia. I. Evidence of a major yield constraint. IX Conferência Internacional de arroz para a América Latina e para o Caribe. V. Reunião Nacional de Pesquisa de Arroz. 21-25 de Març, Goiânia, Goías, Brasil.
18. Gangopadhyay, S., and Chatopadhyay, S. B. 1974. Total silica and brown spot disease development of rice under varying levels of nitrogen. Current Sci. 44:91-94.
19. Hashioka, Y. 1942. Studies on rice blast disease in the tropics. (I) Anatomical comparison of leaf epidermis of Formosan rice with that of Taiwan rice from plant pathological viewpoints. Agric. Hort. 17:846-852.
20. Hemmi, T., Abe, T., and Inoue, Y. 1941. Studies on the rice blast disease: relation of the environment to the development of blast disease and races of the blast fungus. Noji Kairyo Shiryo 157:1–232.
21. Hodson, M. J., and Sangster, A. G. 2002. Silicon and abiotic stress. Pages 99-104 in: Second Silicon in Agriculture Conference. T. Matoh, ed. Press-Net, Kyoto, Japan.
22. Horiguchi, T. 1988. Mechanism of manganese toxicity and tolerance of plants. IV. Effects of silicon on alleviation of manganese toxicity of rice plants. Jpn. J. Soil Sci. Plant Nutr. 34:65-73.
23. Inanaga, S., Okasaka, A., and Tanaka, S. 1995. Does silicon exist in association with organic compounds in rice plant? Jpn. J. Soil Sci. Plant Nutr. 11:111-117.
24. Inokari, G., and Kubota, T. 1930. On the effect of soil dressing and silica application to peatland paddy fields. J. Sapporo Soc. Agric. Sci. 98:484-485.
25. International Rice Research Institute (IRRI) 1993. IRRI Rice Almanac. Los Banos, Laguna, Philippines.
26. International Rice Research Institute (IRRI). 1965. Annual report 1964. Los Banos, Laguna, Philippines.
27. International Rice Research Institute (IRRI). 1966. Annual report 1965. Los Banos, Laguna, Philippines.
28. Ishiguro, K. 2001. Review of research in Japan on the roles of silicon in conferring resistance against rice blast Pages 277-291 in: Silicon in Agriculture. L. E. Datnoff, G. H. Snyder, and G. H. Korndörfer, eds. Studies in Plant Science, Vol. 8. Elsevier Science B. V., Amsterdam, The Netherlands.
29. Ito, S., and Hayashi, H. 1931. On the relation of silica supply to rice blast. J. Sapporo Soc. Agric. Sci. 103:460–461.
30. Ito, S., and Sakamoto, M. 1939. Studies on rice blast. Res. Hokkaido Univ. Bot. Lab. Fac. Agric. Rep., pages 1939–1943.
31. Jones, L. H. P., and Handreck, K. A. 1967. Silica in soils, plants and animals. Ad. Agron. 19:107-149.
32. Juo, A. S. R., and Sanchez, P. A. 1986. Soil nutritional aspects with a view to characterize upland rice environment. Pages 81-95 in: Upland Rice Research. Internat. Rice Res. Inst., Los Banos, Laguna, Philippines.
33. Kang, Y. K. 1980. Silicon influence on physiological activities in rice. Ph.D. diss., University of Arkansas, Fayetteville, Arkansas.
34. Kawamura, E., and Ono, K. 1948. Study on the relation between the pre–infection behavior of rice blast fungus, Piricularia oryzae, and water droplets on rice plant leaves. J. Natl. Agr. Expt. Sta. 4:1–12.
35. Kawashima, R. 1927. Influence of silica on rice blast disease. Jpn. J. Soil Sci. Plant Nutr. 1:86-91.
36. Kim, S. G., Kim, K. W., Park, E. W, and Choi, D. 2002. Silicon–induced cell wall fortification of rice leaves: A possible cellular mechanism of enhanced host resistance to blast. Phytopathology 92:1095-1103.
37. Kitani, K., Natsume, T., and Asaga, K. 1960. Application of calcium silicate to control blast disease of rice. (II) Combined effect of calcium silicate and mercuric fungicide. Shikoku Agric. Res. Shikoku Agric. Res. 6:123-126.
38. Lanning, F. C. 1963. Silicon in rice. J. Agric. Food Chem. 11:435-437.
39. Lee, K. S., Ahn, S. B., Rhee, G. S., Yeon, B. Y., and Park, J. K. 1985. Studies of silica application to nursery beds on rice seedling growth. Farm Prod. Utiliz. 27:23-27.
40. Lee, T. S., Hsu, L. S., Wang, C. C., and Jeng, Y. H. 1981. Amelioration of soil fertility for reducing brown spot incidence in the patty field of Taiwan. J. Agric. Res. China 30:35-49.
41. Liang, Y. C., Shen, Q. R., Shen, Z. G., and Ma, T. S. 1996. Effects of silicon on salinity tolerance of two barley cultivars. J. Plant Nutr. 19:173-183.
42. Ma, J., and Takahashi, E. 1991. Effect of silicate on phosphate availability for rice in a P-deficient soil. Plant Soil 133:151-155.
43. Majumder, N. D., Rakshit, S. C., and Borthakur, D. N. 1985. Genetics of silica uptake in selected genotypes of rice. Plant Soil 88:449-453.
44. Miyaki, K., and Ikeda, M. 1932. Influence of silica application on rice blast. Jpn. J. Soil Sci. Plant Nutr. 6:53-76.
45. Nanda, H. P., and Gangopadhyay, S. 1984. Role of silicated cells in rice leaf on brown spot disease incidence by Bipolaris oryzae. Int. J. Trop. Plant Dis. 2:89-98.
46. Onodera, I. 1917. Chemical studies on rice blast. J. Sci. Agric. Soc. 180:606-617.
47. Osuna-Canizales, F. J., De Datta, S. K., and Bonman, J. M. 1991. Nitrogen form and silicon nutrition effects on resistance to blast disease of rice. Plant Soil 135:223-231.
48. Prabhu, A. S., Barbosa Filho, M. P., Filippi, M. C., Datnoff, L. E., and Snyder, G. H. 2001. Silicon from rice disease control perspective in Brazil. Pages 293-311 in: Silicon in Agriculture. L. E. Datnoff, G. H. Snyder, and G. H. Korndörfer, eds. Studies in Plant Science, Vol. 8. Elsevier Science B. V., Amsterdam, The Netherlands.
49. Rabindra, B., Gowda, S. S., Gowda, K. T. P., and Rajappa, H. K. 1981. Blast disease as influenced by silicon in some rice varieties. Current Res. 10:82-83.
50. Rodrigues, F. Á., Benhamou, N., Datnoff, L. E., Jones, J. B., and Bélanger, R. R. 2003. Ultrastructural and cytochemical aspects of silicon-mediated rice blast resistance. Phytopathology 93:535-546.
51. Rodrigues, F. Á., Datnoff, L. E., Korndörfer, G. H., Seebold, K. W., and Rush, M. C. 2001. Effect of silicon and host resistance on sheath blight development in rice. Plant Dis. 85:827-832.
52. Rodrigues, F. Á., Korndörfer, G. H., Corrêa, G. F., Buki, G. B., Silva, O. A., and Datnoff, L. E. 2001. Response of six gramineae species to application of calcium metasilicate. Page 378 in: Silicon in Agriculture. L. E. Datnoff, G. H. Snyder, and G. H. Korndörfer, eds. Studies in Plant Science, Vol. 8. Elsevier Science B. V., Amsterdam, The Netherlands.
53. Rodrigues, F. Á., McNally, D. J., Datnoff, L. E., Jones, J. B., Labbé, C., Benhamou, N., Menzies, J. G., and Bélanger, R. R. 2004 Silicon enhances the accumulation of diterpenoid phytoalexins in rice: A potential mechanism for blast resistance. Phytopathology 94:177-183.
54. Rodrigues, F. Á., Vale, F. X. R., Korndörfer, G. H., Prabhu, A. S., Datnoff, L. E., Oliveira, A. M. A., and Zambolim, L. 2003. Influence of silicon on sheath blight of rice in Brazil. Crop Prot. 22:23-29.
55. Sanchez, P.A. 1976. Properties and management of soils in the tropics. John Wiley and Sons, New York, London, Sidney, Toronto.
56. Savant, N. K., Datnoff, L. E., and Snyder, G. H. 1997. Depletion of plant-available silicon in soils: A possible cause of declining rice yields. Commun. Soil Sci. Plant Anal. 28:1245-1252.
57. Savant, N. K., Snyder, G. H., and Datnoff, L. E. 1997. Silicon management and sustainable rice production. Pages 151-199 in: Advances in Agronomy, vol. 58. D. L. Sparks ed. Academic Press, San Diego, CA.
58. Schmidt, R. E., Zhang, X., and Chalmers, D. R. 1999. Response of photosynthesis and superoxide dismutase to silica applied to creeping bentgrass grown under two fertility levels. J. Plant Nutr. 22:1763-1773.
59. Seebold, K. W. 1998. The influence of silicon fertilization on the development and control of blast, caused by Magnaporthe grisea (Hebert) Barr, in upland rice. Ph.D. Diss. University of Florida, Gainesville.
60. Seebold, K. W., Datnoff, L. E., Correa-Victoria, F. J., Kucharek, T. A., and Snyder, G. H. 2000. Effect of silicon rate and host resistance on blast, scald, and yield of upland rice. Plant Dis. 84:871-876.
61. Seebold, K. W., Datnoff, L. E., Correa-Victoria, F. J., Kucharek, T. A., and Snyder, G. H. 2004. Effects of silicon and fungicides on the control of leaf and neck blast in upland rice. Plant Dis. 88:253-258.
62. Seebold, K. W., Kucharek, T. A., Datnoff, L. E., Correa-Victoria, F. J., and Marchetti, M. A. 2001. The influence of silicon on components of resistance to blast in susceptible, partially resistant, and resistant cultivars of rice. Phytopathology 91:63-69.
63. Singer, M. J., and Munns, D. N. 1987. Soils: An Introduction. MacMillan, New York.
64. Snyder, G. H., Jones, D. B., and Gascho, G. J. 1986. Silicon fertilization of rice on Everglades Histosols. Soil Sci. Soc. Am. J. 50:1259-1263.
65. Suzuki, H. 1935. The influence of some environmental factors on the susceptibility of the rice plant to blast and Helminthosporium diseases and on the anatomical characters of the plant III. Influence of differences in soil moisture and in amounts of fertilizer and silica given. J. Coll. Agric. 13:277-331.
66. Suzuki, H. 1940. On the relationship between rice susceptibility and penetration into host plants. Ngyo Oyobi Engei 10:1999–2010.
67. Swain, B. N., and Prasad, J. S. 1988. Influence of silica content in the roots of rice varieties on the resistance to root-knot nematodes. Ind. J. Nematol. 18:360-361.
68. Takahashi, E. 1995. Uptake mode and physiological functions of silica. Sci. Rice Plant 2:58-71.
69. Takahashi, Y. 1967. Nutritional studies on development of Helminthosporium leaf spot. Pages 157-170 in: Proceedings of the Symposium on Rice Diseases and Their Control by Growing Resistant Varieties and Other Measures. Agric., Forestry, and Fisheries Res. Counc., Tokyo, Japan.
70. Tamai, K., and Ma, J. F. 2003. Characterization of silicon uptake by rice roots. New Phytologist 158:431-436.
71. Volk, R. J., Kahn, R. P., and Weintraub, R. L. 1958. Silicon content of the rice plant as a factor in influencing its resistance to infection by the rice blast fungus, Piricularia oryzae. Phytopathology 48:121-178.
72. Wang, H., Li, C., and Liang, Y. 2001. Agricultural utilization of silicon in China. Pages 343-358 in: Silicon in Agriculture, Eds. L. E. Datnoff, G. H. Snyder and G. H. Korndorfer, Elsevier Science, The Netherlands.
73. Winslow, M. D. 1992. Silicon, disease resistance, and yield of rice genotypes under upland cultural conditions. Crop Sci. 32:1208-1213.
74. Winslow, M. D. 1995. Silicon: a new macronutrient deficiency in upland rice. International Center for Tropical Agriculture. Working Document No. 149, Cali, Colombia.
75. Yoshida, S. 1965. Chemical aspects of the role of silicon in physiology of the rice plant. Bull. Natl. Inst. Agric. Sci. Ser. 15:1-58.
76. Yoshida, S., Ohnishi, Y., and Kitagishi, K. 1962. Chemical forms, mobility, and deposition of silicon in the rice plant. Jpn. J. Soil Sci. Plant Nutr. 8:107-111.
